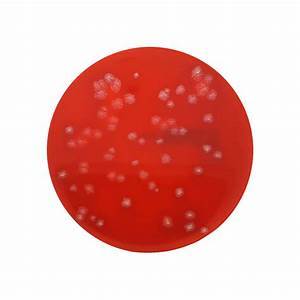

कोलंबिया एगर (भेड़ का खून 5%) +वैनकोमाइसिन अनुप्रयोग: Na
प्राइस: 1800 INR
स्टॉक में
| वर्गीकरण | अन्य |
| शेल्फ लाइफ | 1महीने |
| मेल्टिंग पॉइंट | NA |
| भौतिक रूप | अन्य |
| शुद्धता (%) | NA |
विस्तृत जानकारी
| वर्गीकरण | अन्य |
| शेल्फ लाइफ | 1महीने |
| मेल्टिंग पॉइंट | NA |
| भौतिक रूप | अन्य |
| शुद्धता (%) | NA |
| दुसरे नाम | NA |
| एच एस कोड | 3822 |
| रासायनिक नाम | अन्य |
| स्वाद | अन्य |
| स्ट्रक्चरल फॉर्मूला | NA |
| टाइप करें | MICROBIOLOGY |
| पीएच लेवल | NA |
| ईआईएनईसीएस नं | NA |
| रंग | NA |
| आण्विक सूत्र | NA |
| कैस नं | NA |
| क्वथनांक | NA |
| एप्लीकेशन | NA |
| शेप | दूसरा |
| दिखावट | NA |
| आपूर्ति की क्षमता | 1000प्रति दिन |
| नमूना नीति | यदि आदेश की पुष्टि हो जाती है तो हम नमूना लागत की प्रतिपूर्ति करेंगे |
| प्रमाणपत्र | DELIVER READY IN STOCK |
| डिलीवरी का समय | 10-15दिन |
| भुगतान की शर्तें | चेक, कैश ऑन डिलीवरी (COD), कैश अगेंस्ट डिलीवरी (CAD), कैश एडवांस (CA) |
| नमूना उपलब्ध | 1 |
| पैकेजिंग का विवरण | 20 PLATE |
| मुख्य घरेलू बाज़ार | ऑल इंडिया |
| एफओबी पोर्ट | DELHI |
कंपनी का विवरण
व्यापार के प्रकार
आयातक, वितरक, आपूर्तिकर्ता, व्यापार कंपनी
कर्मचारी संख्या
25
स्थापना
2012
कार्य दिवस
सोमवार से रविवार
जीएसटी सं
07BXSPD1989H1ZY
विक्रेता विवरण
सर ग्रुप
जीएसटी सं
07BXSPD1989H1ZY
रेटिंग
4
नाम
रामभजन द्विवेदी
पता
प्लाट नो- ड़१७/६३ रोहिणी सेक्टर ३, नियर राम लीला पार्क, दिल्ली, दिल्ली, 110085, भारत
गलत विवरण की रिपोर्ट करें
संबंधित उत्पाद
विश्लेषणात्मक परीक्षण प्रयोगशालाएं
Price - 199 INR
MOQ - 1 Piece/Pieces
अक्षर एनालिटिकल लेबोरेटरी एंड रिसर्च सेंटर
अहमदाबाद, Gujarat
विश्लेषणात्मक परीक्षण प्रयोगशालाएं
Price - 199 INR
MOQ - 1 Piece/Pieces
ज. क. एनालिटिकल लेबोरेटरी एंड रिसर्च सेंटर
अहमदाबाद, Gujarat
विश्लेषणात्मक परीक्षण प्रयोगशालाएँ
अनुसन्धान एनालिटिकल एंड बायोकैमिकल रिसर्च लेबोरेटरी प्राइवेट लिमिटेड
इंदौर, Madhya Pradesh
स्पेक्ट्रोस्कोपिक विश्लेषण द्वारा पॉलिमर यौगिकों की पहचान: एफटीआईआर विश्लेषण
जापान पॉलीमर एनालिटिकल एंड रिसर्च लेबोरेटरी इंडिया पवत. ल्टड.
चेन्नई, Tamil Nadu